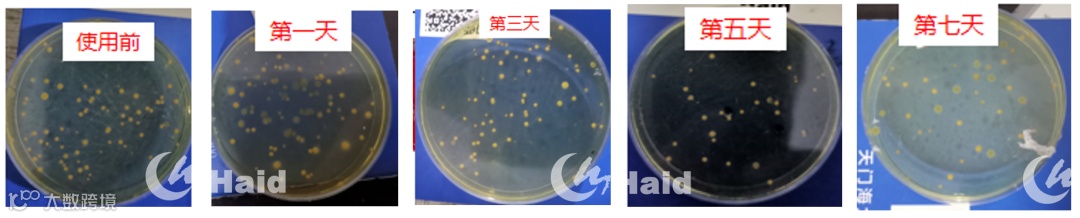

文 | 图 天门海大 朱方正 毛义波
一、当前养殖痛点
7-9月份,华中地区水产养殖进入高投喂期,池塘负荷日益加重;加之气温上升,天气变化,池塘水质问题也随之严重,池塘普遍出现死藻、油膜以及亚盐超标现象;更为关键的是,由水质问题所导致的鱼类吃食差、加料难,成为当前养殖主要痛点。
二、水质不稳,危机重重

主要危害有以下几点:
1、吃食不稳定:天气变化,溶氧波动较大,雨天、高温天影响投喂;
2、浓绿水频发:尤其在高温天气下,藻类繁殖代谢加快,如不调控好水质,则普遍容易产生浓绿水;
3、亚盐难降:亚盐超标,严重时影响鱼类正常吃食,甚至诱发疾病、中毒死亡。而且,随着投喂量加大,池塘底部粪便、有机残渣堆积越来越多,底部耗氧严重、细菌繁殖加快、进一步恶化池塘环境,导致鱼类吃食差、加料难。
三、何以解忧?海大罗氏“3+1”
面对以上池塘常见问题,海大集团技术研发团队经过多年研发,以及在养殖实践中不断进行方案优化,全新推出实用性更强、性价比更高的“海大罗氏3+1”方案。


其主要通过分解、利用粪便残饵“变废为宝”,快速高效将残饵、粪便、死藻等有机质,转化成小分子物质,不仅为藻类生长提供营养物质,还能继续形成生物絮团,被鱼类摄食,促进消化,提高投喂量。更重要的是,长期使用海大罗氏“3+1”,使得水体生态养殖环境维持一个相对平衡状态,这个平衡状态就是我们常说的“菌藻平衡”。
四、海大罗氏3+1,小水体验证
为了更直观的展现海大罗氏3+1方案对水质变化的效果,我们模拟池塘环境,进行了小水体实验,试验组为使用海大罗氏3+1方案的水体,对照组为未使用海大罗氏3+1方案的水体。
使用海大罗氏3+1方案后,产生大量絮凝物

使用”海大罗氏3+1“方案后第3天,水体悬浮物明显增多,出现大量白色、成团絮凝物。这说明,在实际养殖中,这些被分解的有机物、老化的藻类、菌体蛋白等在海大罗氏3+1组合产品的作用下絮凝成团,以供花白鲢,甚至草鱼、鲫鱼等吃食鱼类摄食。
使用海大罗氏3+1方案后,早晚pH波动减小

连续跟进发现,使用”海大罗氏3+1“方案后,可以明显降低pH的波动幅度,说明在实际养殖中,可以有效减轻pH的剧烈变化对鱼体的应激。
使用海大罗氏3+1方案后,明显降低亚盐浓度

使用海大罗氏3+1方案后第1天,亚盐即开始显著降低,但在第7天开始反弹,说明在实际养殖中,海大罗氏3+1方案的使用频率应控制在7天之内。
小水体实验表明
1、可将池塘的粪便、残饵变废为宝,转化为可供花白鲢等吃的高蛋白营养物质;
2、可有效降低池塘pH的波动,减少pH的波动对鱼体的应激;
3、可有效降低池塘亚盐浓度。
五、海大罗氏3+1,大塘效果跟进
肥水效果显著,藻类丰度明显增加

使用“海大罗氏3+1”后,池塘水色发生明显变化,在使用后的第1天,藻类丰度显著增加。但随着时间的延长,其水色逐渐变淡,实际操作中建议使用频率控制在5-7天/次。
显著增加池塘溶氧

使用“海大罗氏3+1”后,可以显著提升池塘上、下层水的溶氧浓度,对老塘效果更明显;说明使用海大罗氏3+1后,可以将池塘底部大量有机物,转化为藻类的营养成分,且能有效降低池塘底部耗氧情况。
有效降低亚盐、氨氮浓度

使用“海大罗氏3+1”后,可以显著降低池塘氨氮、亚盐浓度;但对于亚盐较高的池塘(代XX),在使用后的第7天,其亚盐开始反弹。
而在对同一客户同一池塘(代XX)的持续跟进中,我们发现,定期使用”海大罗氏3+1”方案(5-7日/次),可以有效降低亚盐含量,并且将亚盐浓度持续稳定在正常范围(≤0.2mg/L)。这说明海大罗氏3+1方案可以有效降低池塘亚盐,并且定期使用可将亚盐浓度持续稳定在正常范围。

抑制有害菌(嗜水气单胞菌)的生长
使用“海大罗氏3+1”后,池塘病原菌显著减少,说明海大罗氏3+1组合中的有益菌通过生态占位、营养竞争和分泌代谢物可以有效抑制病原菌繁殖。
阴雨天稳投喂,减少天气变化对投喂的影响

使用“海大罗氏3+1”方案的客户,投喂并未受到阴雨天影响,而未使用海大罗氏3+1方案的池塘,投喂量减少30%左右,明显受到阴雨天的影响.
定期使用有效促进投喂、并降低改底频率


与未使用“海大罗氏3+1”客户相比,定期使用“海大罗氏3+1”方案的池塘:其投饵率高0.39%;每月改底频率下降了约50%;说明“海大罗氏3+1”可以有效的提高投饵率、促进鱼吃食,并且降低改底频率,节约改底成本。
使用“海大罗氏3+1”方案后
1、肥水:可有效促进藻类的生长、肥水效果显著,建议5-7天使用一次;
2、增氧:可明显提升水体溶氧,显著提升池塘底部溶氧情况,且对老塘效果更明显;
3、稳水:使用海大罗氏3+1后,可以显著降低池塘氨氮、亚盐浓度;但对于亚盐较高的池塘,在使用后的第7天,其亚盐开始反弹;说明该方案使用频率控制在7日以内为宜;
4、抑菌:使用海大罗氏3+1方案后,池塘病原菌显著减少,说明海大罗氏3+1中的有益菌类通过生态占位、营养竞争和分泌代谢物可以有效抑制病原菌繁殖;
5、阴雨天稳投:使用海大罗氏3+1方案后,投喂并未受到阴雨天影响,而未使用海大罗氏3+1方案的池塘,投喂量减少30%左右,明显受到阴雨天的影响;
6、定期使用促进投喂:使用海大罗氏3+1方案的客户,其投饵率比未使用海大罗氏3+1方案的客户高0.39%、每月改底频率下降50%。
六、稳水促投效果明显,客户好评如潮

一大波好评席卷华中大地
2021,是水产养殖“大年”,在多年一遇的行情下,我们不能向以往一样,还在因为浓绿水、油膜水、亚盐超标等水质问题,持续影响饲料的投喂。而“海大罗氏3+1”可以有效的稳定水质,促进投喂。当然,在2021年如此牛气冲天的行情下,我们除了稳定好水质,保障投喂外;同时也要使用好海大高档膨化料,以此来达到抢规格、抢价格、抢效益的养殖策略。
海大农牧
接地气的水产一线技术
长摁二维码,即刻关注

